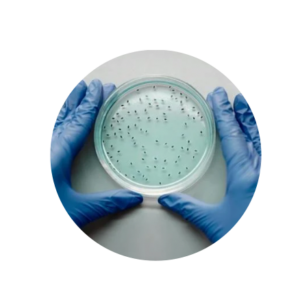

A l’intégration d’un nouveau collaborateur, lors de la mise en œuvre d’un nouveau service, ou dans le cadre du maintien des connaissances et du développement des compétences, la formation est une étape essentielle pour délivrer un service professionnel et efficace.
En complément des parrainages et des accompagnements que vous pouvez mettre en œuvre au sein de votre organisation, ADEOVIA vous aide à faire monter en compétence vos équipes sur les sujets techniques, commerciaux et réglementaires, de façon pragmatique.
Les programmes de formation d’ADEOVIA intègrent et développent comment les pratiques et méthodes de travail évoluent, se modifient, et s’intègrent dans la TRANSITION ECOLOGIQUE.
De ce fait, nos formations restent éligibles au financement par l’OPCO EP et AKTO.

Découvrez nos formations CERTIBIOCIDES :
Découvrez toutes nos formations TECHNIQUES :
Nous construisons les modules de formation sur mesure, en fonction de vos besoins et de vos spécificités. N’hésitez pas à nous consulter !